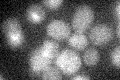
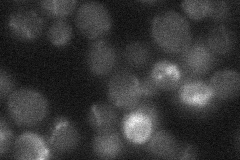

View description
Cell-cycle regulated activator of the anaphase-promoting complex/cyclosome (APC/C), which directs ubiquitination of cyclins resulting in mitotic exit; targets the APC/C to specific substrates including Cdc20p, Ase1p, Cin8p and Fin1p
Localization:
Intensity:
Fold change:
Significance:
-
C’ GFP library in SD
below threshold15.77 -
N' NOP1pr-GFP in SD

nucleus31.335 -
N' TEF2pr-mCherry in SD

nucleus32.3692 -
N' NATIVEpr-GFP in SD
below threshold17.8841 -
N' TEF2pr-VC and Cyto-VN in SD

below threshold25.4123 -
C’ GFP library in SD+DTT

cytosol18.261.15No -
C’ GFP library in SD+H2O2

cytosol15.760.99No -
C’ GFP library in Starvation Media

cytosol25.251.6No -
C’ GFP library on the background of Pup2-DaMP

below threshold -
C’ GFP library on the background of CCT mutant

below threshold17.23611.09265No
